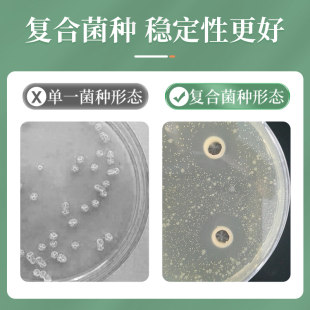

Китайская ткань ветеринарной наркотики животных впрыск Используйте жидкую свинину, крупный рогатый скот, овцы, голуби -голуби для кошек увеличивают аппетит и разрешают жесткую устойчивость к всплеску иммунитета
Код товара:
652434397375
Цена:
1,130 руб.